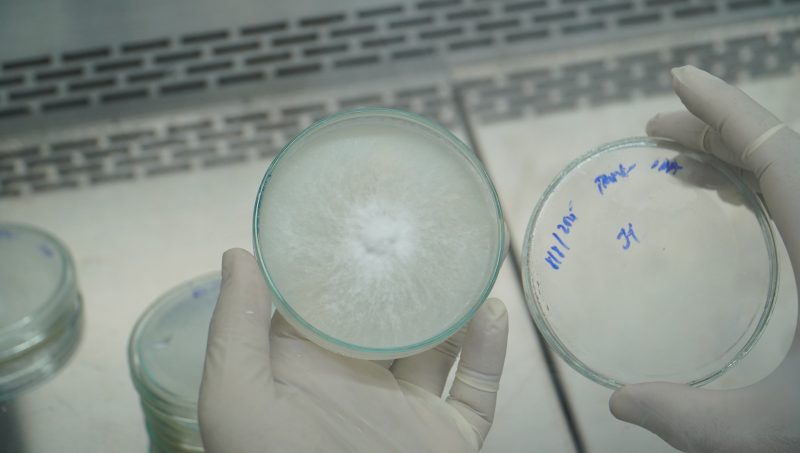
Nghiên cứu thành công giai đoạn 2 giống nấm hương (Lentinula edodes) 40 Dsc07373

Tin tức – Sự kiện QTU
Trường Đại học Quang Trung ổn định hoạt động giảng dạy sau bão số 13 Đọc thêm »
Thể lệ và cách thức đăng ký cuộc thi GEN TEA 2025 Đọc thêm »
Cuộc thi GEN TEA mở đầu cho chuỗi Lễ hội Trà Quốc tế World Tea Fest 2025 Đọc thêm »
Trường Đại học Quang Trung là đối tác tổ chức cuộc thi GEN TEA 2025 Đọc thêm »
QTU – Chung tay vượt qua sau bão số 13 Đọc thêm »
Trường Đại học Quang Trung khẩn trương triển khai công tác phòng, chống bão số 13 Đọc thêm »
Thông báo nghỉ học toàn trường Đọc thêm »
Sinh viên QTU trải nghiệm thực tế nghề Tài chính – Kế toán tại Nam A Bank Quy Nhơn Đọc thêm »
Nghiên cứu thành công giai đoạn 2 giống nấm hương (Lentinula edodes) Đọc thêm »
Trường Đại học Quang Trung hợp tác với 9 doanh nghiệp Đọc thêm »
Tân Hiệu trưởng Trường Đại học Quang Trung Đọc thêm »